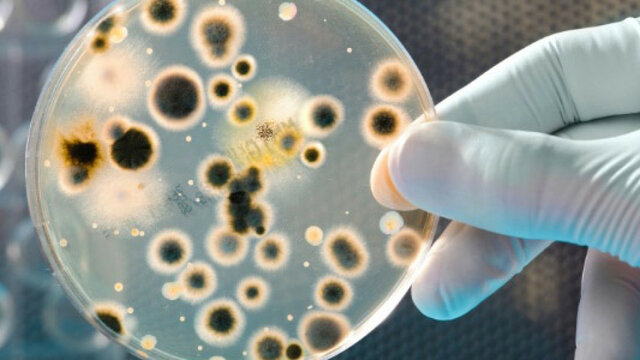
Robert Koch
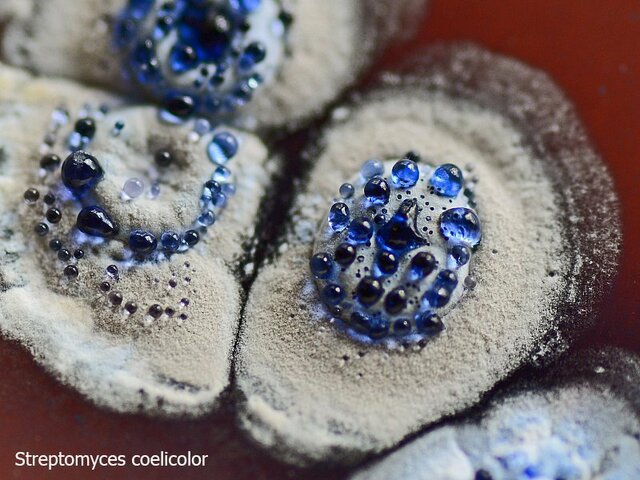
Hopwood y Col

-
 Fracastoro escribió, hasta donde sabemos, dos obras sobre la sífilis. Propone que las enfermedades están causadas por organismos invisibles.
Fracastoro escribió, hasta donde sabemos, dos obras sobre la sífilis. Propone que las enfermedades están causadas por organismos invisibles. -
 el inventor del microscopio. Janssen provenía de una familia de fabricantes de lentes y fue él quien desarrolló el microscopio, comenzando a utilizarlo en 1595, quince años antes de la fecha que se maneja según la teoría de la invención por Galileo
el inventor del microscopio. Janssen provenía de una familia de fabricantes de lentes y fue él quien desarrolló el microscopio, comenzando a utilizarlo en 1595, quince años antes de la fecha que se maneja según la teoría de la invención por Galileo -
 Primero en refutar la teoría de la generación expontanea en gusanos.
Primero en refutar la teoría de la generación expontanea en gusanos. -
 Fue el primero en observar bacterias o animaliculos".
Fue el primero en observar bacterias o animaliculos". -
 Desarrollo la primera vacuna contra la viruela humana.
Desarrollo la primera vacuna contra la viruela humana. -
 Descubrió un hongo (phytophthora infestans) que produce la podredumbre de la patata.
Descubrió un hongo (phytophthora infestans) que produce la podredumbre de la patata. -
 Realiza el primer estudio Epidemiológico del cólera en Londres.
Realiza el primer estudio Epidemiológico del cólera en Londres. -
 Propone la utilización de antisépticos para evitar la fiebre puerperd.
Propone la utilización de antisépticos para evitar la fiebre puerperd. -
 Refuta de manera convincente la teoría de la generación expontánea. Más info en:
Refuta de manera convincente la teoría de la generación expontánea. Más info en:
https://www.lavanguardia.com/historiayvida/historia-contemporanea/20191125/471784509786/louis-pasteur-generacion-espontanea.html -
 Descubre el DNA(ácido nucleiclo) en el esperma de trucha
Descubre el DNA(ácido nucleiclo) en el esperma de trucha -
 Demuestra que el carbunco o ántrax es causado por Bacillus anthracis
Demuestra que el carbunco o ántrax es causado por Bacillus anthracis -
 Observó que la fiebre amarilla era transmitida por mosquitos.
Observó que la fiebre amarilla era transmitida por mosquitos. -
Cultiva bacterias sobre gelatina.
Cultiva bacterias sobre gelatina.
Más información en: https://www.hispanagar.com/es/como-surgio-el-primer-medio-de-cultivo-con-agar -
 Descubre el bacilo de la mhcobacterium tuberculosis
Descubre el bacilo de la mhcobacterium tuberculosis -
 Se desarrolla la tincion de gram. (identificador de bacterias) más info en: https://www.google.com/amp/s/elpais.com/sociedad/2019/09/13/actualidad/1568359007_968117.html%3foutputType=amp
Se desarrolla la tincion de gram. (identificador de bacterias) más info en: https://www.google.com/amp/s/elpais.com/sociedad/2019/09/13/actualidad/1568359007_968117.html%3foutputType=amp -
 Puso a punto la vacuna contra la rabia.
Puso a punto la vacuna contra la rabia.
Más info en:https://www.udep.edu.pe/hoy/2020/10/pasteur-y-la-vacuna-antirrabica/ -
 Descubre la Escheria coli. (es una Bacteria productora de toxina Shiga, que puede causar graves enfermedades a través de los alimentos.
Descubre la Escheria coli. (es una Bacteria productora de toxina Shiga, que puede causar graves enfermedades a través de los alimentos. -
 Introduce el uso de las placas petri en microbiología.Esta placa se utiliza con distintas finalidades: Para cultivar bacterias, mohos y otros microorganismos, cubriendo el fondo con algún método de cultivo como agar entre otras.
Introduce el uso de las placas petri en microbiología.Esta placa se utiliza con distintas finalidades: Para cultivar bacterias, mohos y otros microorganismos, cubriendo el fondo con algún método de cultivo como agar entre otras. -
 Aísla bacterias fijador as de nitrógeno de los nódulos presentes en las raíces de las leguminosas. Puedes ver más sobre este tema en:https://arbor.revistas.csic.es/index.php/arbor/article/view/2123/2792
Aísla bacterias fijador as de nitrógeno de los nódulos presentes en las raíces de las leguminosas. Puedes ver más sobre este tema en:https://arbor.revistas.csic.es/index.php/arbor/article/view/2123/2792 -
 Estudio las bacterias del azufre y las bacterias nitrificantes...... http://www.mailxmail.com/curso-microbiologia-organismos-2-2/microbiologia-aislar-bacterias
Estudio las bacterias del azufre y las bacterias nitrificantes...... http://www.mailxmail.com/curso-microbiologia-organismos-2-2/microbiologia-aislar-bacterias -
 Demuestra que el mosaico del tabaco es producido por un virus.
Demuestra que el mosaico del tabaco es producido por un virus. -
 Demuestran que el treponema páladium es el agente productor de la sífilis (ETS).
Demuestran que el treponema páladium es el agente productor de la sífilis (ETS). -
 Demuestra que la fiebre de las montañas rocosas es transmitida por garrapatas, y aisló el microorganismo causante de la enfermedad am cual el llamó (rickettsia). Y el falleció por esa enfermedad :( más info en:https://www.lib.uchicago.edu/collex/exhibits/researching-mexico-university-chicago-field-explorations-mexico-1896-2014/howard-taylor-ricketts/#:~:text=A%20principios%20del%20siglo%20XX,fiebre%20de%20las%20Monta%C3%B1as%20Rocosas'.
Demuestra que la fiebre de las montañas rocosas es transmitida por garrapatas, y aisló el microorganismo causante de la enfermedad am cual el llamó (rickettsia). Y el falleció por esa enfermedad :( más info en:https://www.lib.uchicago.edu/collex/exhibits/researching-mexico-university-chicago-field-explorations-mexico-1896-2014/howard-taylor-ricketts/#:~:text=A%20principios%20del%20siglo%20XX,fiebre%20de%20las%20Monta%C3%B1as%20Rocosas'. -
 Descubre el salvarsán (balas mágicas). Primer agente quimioterapéutico contra la sífilis. Más info en: https://www.agenciasinc.es/Visual/Fotografias/La-primera-bala-magica-del-Dr.-Ehrlich
Descubre el salvarsán (balas mágicas). Primer agente quimioterapéutico contra la sífilis. Más info en: https://www.agenciasinc.es/Visual/Fotografias/La-primera-bala-magica-del-Dr.-Ehrlich -
 Descubre el virus (retro virus) que produce tumores (sarcoma) en los pollos.
Descubre el virus (retro virus) que produce tumores (sarcoma) en los pollos. -
 Descubre los virus que infectan bacterias (bacteriófagos). Más info en : https://www.ciad.mx/notas/item/2451-bacteriofagos-y-depolimerasas-armas-potenciales-en-la-guerra-contra-las-bacterias
Descubre los virus que infectan bacterias (bacteriófagos). Más info en : https://www.ciad.mx/notas/item/2451-bacteriofagos-y-depolimerasas-armas-potenciales-en-la-guerra-contra-las-bacterias -
 Se publica por primera vez el manual Bergey de microbiología.
Se publica por primera vez el manual Bergey de microbiología. -
 Lleva a cabo el descubrimiento de las transformaciones bacterianas.
Lleva a cabo el descubrimiento de las transformaciones bacterianas. -
 Aísla la penicilina de un cultivo de penicilium notatum
Aísla la penicilina de un cultivo de penicilium notatum -
 Desarrolla el microscopio de contraste de fases que permite ver microorganismos vivos.
Desarrolla el microscopio de contraste de fases que permite ver microorganismos vivos. -
 Inventa el microscopio electrónico. Más info en:https://traductordeciencia.es/como-funciona-un-microscopio-electronico/
Inventa el microscopio electrónico. Más info en:https://traductordeciencia.es/como-funciona-un-microscopio-electronico/ -
 Consigue cristalizar el virus del mosaico del tabaco (que permaneció activo después de la cristalización).
Consigue cristalizar el virus del mosaico del tabaco (que permaneció activo después de la cristalización). -
 Descubre las sulfamidas, el primer agente quimioterapéutico.
Descubre las sulfamidas, el primer agente quimioterapéutico. -
 Aísla la estreptomicina de un cultivo de streptomyces griseus.su jefe. Selman Waksman se apodera del descubrimiento y gana el premio nobel de medicina 1952.:( la historia de como sucedió: https://miradorsalud.com/la-triste-historia-del-descubrimiento-de-la-estreptomicina/
Aísla la estreptomicina de un cultivo de streptomyces griseus.su jefe. Selman Waksman se apodera del descubrimiento y gana el premio nobel de medicina 1952.:( la historia de como sucedió: https://miradorsalud.com/la-triste-historia-del-descubrimiento-de-la-estreptomicina/ -
 Demuestran la existencia de conjugación en escherichia coli
Demuestran la existencia de conjugación en escherichia coli -
 Estudio el fenómeno de la lisogenia.http://bibliotecadigital.ilce.edu.mx/sites/ciencia/volumen2/ciencia3/071/htm/sec_8.htm
Estudio el fenómeno de la lisogenia.http://bibliotecadigital.ilce.edu.mx/sites/ciencia/volumen2/ciencia3/071/htm/sec_8.htm -
 Descubren el fenómeno de la transducción generalizada.
Descubren el fenómeno de la transducción generalizada. -
 Introduce el concepto de plasmido
Introduce el concepto de plasmido -
 Consiguen dilucidar la estructura en doble hélice del DNA.
Consiguen dilucidar la estructura en doble hélice del DNA. -
 Demuestran la existencia del plasmido F en Echerichia coli.
Demuestran la existencia del plasmido F en Echerichia coli. -
 Proporcionan el primer ejemplo de control de la expresión de genes a nivel de transcripción: modelo del operón.
Proporcionan el primer ejemplo de control de la expresión de genes a nivel de transcripción: modelo del operón. -
 Descubren que el codón UUU codificaba para el aminoácido fenilafanina. Experimento que sentó a las bases para la elucidación del código genético.
Descubren que el codón UUU codificaba para el aminoácido fenilafanina. Experimento que sentó a las bases para la elucidación del código genético. -
 Aísla los tRNA, moléculas que incorporan los aminoácidos activados en las proteínas.
Aísla los tRNA, moléculas que incorporan los aminoácidos activados en las proteínas. -
 Descubren las enzimas de restricción, herramientas esenciales, para el desarrollo de la ingeniería genética
Descubren las enzimas de restricción, herramientas esenciales, para el desarrollo de la ingeniería genética -
 Pone a punto un test bacteriano para detectar mutagenos y carcinógenos.
Pone a punto un test bacteriano para detectar mutagenos y carcinógenos. -
 Reconocen las archeas como el tercer dominio de los seres vivos.
Reconocen las archeas como el tercer dominio de los seres vivos. -
 Desarrolla el método de los oide oxinucleótidos para la secuenciacion del DNA.
Desarrolla el método de los oide oxinucleótidos para la secuenciacion del DNA. -
 Descubre los priones, agentes causantes de la encefalopatía espongiforme bovina y de la enfermedad de Creutzfetdt Jakob.
Descubre los priones, agentes causantes de la encefalopatía espongiforme bovina y de la enfermedad de Creutzfetdt Jakob. -
 Llevan a cabo el aislamiento e identificación del virus del sida.
Llevan a cabo el aislamiento e identificación del virus del sida. -
 Demuestran el papel de la Helicobacter pylori en la úlcera del estómago.más info en: https://medlineplus.gov/spanish/ency/article/007715.htm#:~:text=Helicobacter%20pylori%20(H%20pylori)%20es,la%20mayor%C3%ADa%20de%20las%20personas.
Demuestran el papel de la Helicobacter pylori en la úlcera del estómago.más info en: https://medlineplus.gov/spanish/ency/article/007715.htm#:~:text=Helicobacter%20pylori%20(H%20pylori)%20es,la%20mayor%C3%ADa%20de%20las%20personas. -
 Descubren Epulopiscium fishelsoni, la mayor célula procariota.as info en:https://elpais.com/diario/1993/03/18/sociedad/732409205_850215.html
Descubren Epulopiscium fishelsoni, la mayor célula procariota.as info en:https://elpais.com/diario/1993/03/18/sociedad/732409205_850215.html -
 Se secuencia el genoma de la Bacteria Haemophilus influenzae.as info en:https://www.elmundo.es/ciencia/genoma/cronologia.html
Se secuencia el genoma de la Bacteria Haemophilus influenzae.as info en:https://www.elmundo.es/ciencia/genoma/cronologia.html -
 Se secuencia el genoma de la Bacteria Sacchomyces cerevisiae.
Se secuencia el genoma de la Bacteria Sacchomyces cerevisiae. -
 Se secuencia el genoma de la Bacteria Escherichia coli. pertenece a las entero bacterias, una familia de bacterias compuesta por numerosas especies de bacterias gramnegativas.
Se secuencia el genoma de la Bacteria Escherichia coli. pertenece a las entero bacterias, una familia de bacterias compuesta por numerosas especies de bacterias gramnegativas. -
 Se descubre la Bacteria gigante Thiomargarita namebiensis. Más info en https://zientzia.eus/artikuluak/namibiako-bakterio-erraldoia/es/
Se descubre la Bacteria gigante Thiomargarita namebiensis. Más info en https://zientzia.eus/artikuluak/namibiako-bakterio-erraldoia/es/ -
 Descubrieron que vibrio cholerae (La bacteria que causa la infección por cólera) tiene dos cromosomas circulares.
Descubrieron que vibrio cholerae (La bacteria que causa la infección por cólera) tiene dos cromosomas circulares. -
Realizaron la secuenciacion del genoma Streptomyces Coelicolor. Se trata de un microorganismo a partir del cual se producen antibióticos naturales. Más info en:https://www.intramed.net/contenidover.asp?contenidoid=18749
Realizaron la secuenciacion del genoma Streptomyces Coelicolor. Se trata de un microorganismo a partir del cual se producen antibióticos naturales. Más info en:https://www.intramed.net/contenidover.asp?contenidoid=18749 -
 Aparece en Asia la gripe aviar. Producida por el subtipo H5N1 del virus influenzae a que puede transmitir e al hombre. Detectado principalmente en aves. Más info en: https://espanol.cdc.gov/flu/avianflu/h5n1-virus.htm
Aparece en Asia la gripe aviar. Producida por el subtipo H5N1 del virus influenzae a que puede transmitir e al hombre. Detectado principalmente en aves. Más info en: https://espanol.cdc.gov/flu/avianflu/h5n1-virus.htm -
 La secuenciación del genoma de legionella pneumophila, el microorganismo productor de la enfermedad de los legionarios.
La secuenciación del genoma de legionella pneumophila, el microorganismo productor de la enfermedad de los legionarios. -
 se secuencia el genoma del saccharopolyspora erythraea el microorganismo productor del antibiótico eritromicina
se secuencia el genoma del saccharopolyspora erythraea el microorganismo productor del antibiótico eritromicina -
 Se descubre el proceso de esporulación en mycobacterium. Más info en:https://cordis.europa.eu/article/id/30887-discovery-of-mycobacteria-spore-formation-sheds-light-on-tuberculosis/es
Se descubre el proceso de esporulación en mycobacterium. Más info en:https://cordis.europa.eu/article/id/30887-discovery-of-mycobacteria-spore-formation-sheds-light-on-tuberculosis/es -
 Caracterización "in vitro" e "in vivo" del virus H1N1.
Caracterización "in vitro" e "in vivo" del virus H1N1. -
 el Gran Colisionador de Hadrones -un enorme anillo de más de 30 kilómetros ubicado a cien metros bajo tierra en la frontera franco-suiza- comenzó a reproducir "mini big bangs" para estudiar el origen del universo.El objetivo es analizar esos choques, que podrían revelar partículas desconocidas hasta ahora, entre ellas la "partícula divina", o bosón de Higgs
el Gran Colisionador de Hadrones -un enorme anillo de más de 30 kilómetros ubicado a cien metros bajo tierra en la frontera franco-suiza- comenzó a reproducir "mini big bangs" para estudiar el origen del universo.El objetivo es analizar esos choques, que podrían revelar partículas desconocidas hasta ahora, entre ellas la "partícula divina", o bosón de Higgs -
 La compañía biofarmacéutica Geron Corporation, de California, intentará restaurar la sensibilidad y el movimiento de ciertos miembros en pacientes con lesiones graves de médula espinal.
La compañía biofarmacéutica Geron Corporation, de California, intentará restaurar la sensibilidad y el movimiento de ciertos miembros en pacientes con lesiones graves de médula espinal.
Este ensayo, el primero de esta índole autorizado por la Administración de Alimentos y Fármacos de EE.UU. (FDA, por sus siglas en inglés), suscitó un intenso debate ético -
 "Nace" la primera célula viva con ADN sintético. por primera vez, este investigador y empresario estadounidense había conseguido trasplantar ADN artificial –una especie de "software genético"- en una célula.
"Nace" la primera célula viva con ADN sintético. por primera vez, este investigador y empresario estadounidense había conseguido trasplantar ADN artificial –una especie de "software genético"- en una célula. -
 responsable del blog "Microbichitos", que ofrece una guía para entender cómo viven y cómo nos afectan los microbios, desde lo que comemos hasta las enfermedades que sufrimos. Un texto asequible, pero también riguroso, ameno y actualizado de la microbiología dirigida al público interesado en conocer el mundo de los microorganismos.
responsable del blog "Microbichitos", que ofrece una guía para entender cómo viven y cómo nos afectan los microbios, desde lo que comemos hasta las enfermedades que sufrimos. Un texto asequible, pero también riguroso, ameno y actualizado de la microbiología dirigida al público interesado en conocer el mundo de los microorganismos. -
 La Bacteria del Arsénico.
La Bacteria del Arsénico.
científicos de la NASA habían encontrado una bacteria capaz de usar el arsénico en sustitución del fósforo, sobre todo en su DNA -
 El genoma del denisovano, secuenciado.
El genoma del denisovano, secuenciado.
logró secuenciar el genoma del homínido de Denisova, una misteriosa especie encontrada en 2010 en Siberia y emparentada con los neandertales, a partir de un fragmento de un dedo meñique infantil y dos piezas dentales. -
 Científicos japoneses de la Universidad de Kioto consiguieron fabricar en el laboratorio óvulos fértiles , con capacidad para ser fecundados, a partir de células madre de ratón. Los óvulos dieron lugar a una amplia descendencia de ratoncillos sanos
Científicos japoneses de la Universidad de Kioto consiguieron fabricar en el laboratorio óvulos fértiles , con capacidad para ser fecundados, a partir de células madre de ratón. Los óvulos dieron lugar a una amplia descendencia de ratoncillos sanos -
 La inmunoterapia del cáncer.
La inmunoterapia del cáncer.
El método consiste en influir al sistema inmunológico del paciente en vez de impactar el propio tumor, de manera que sea el mismo sistema de la persona el que empiece a luchar contra las células cancerígenas. Tras décadas de estudios, últimamente los científicos han logrado comprobar que el cáncer de varios pacientes ha sido curado precisamente por efecto de la inmunoterapia, algo que la convierte en el punto de viraje para los estudios de esta enfermedad. -
 El método puede 'editar' los genes cambiando el 'texto genético' del ADN y sin causar ningún tipo de mutación no deseada. La técnica aplica una proteína Cas9, la cual es usada por las bacterias como una herramienta para 'cortar' el ADN de virus depredadores.
El método puede 'editar' los genes cambiando el 'texto genético' del ADN y sin causar ningún tipo de mutación no deseada. La técnica aplica una proteína Cas9, la cual es usada por las bacterias como una herramienta para 'cortar' el ADN de virus depredadores. -
 se completó el primer mapa del epigenoma humano, es decir el registro de los cambios químicos en material genético, equivalentes a interruptores moleculares de los genes, lo que permitiría avanzar en la investigación del cáncer a partir de células madre para formar folículos pilosos, lo que apunta a generar el crecimiento de cabello en personas que padecen calvicie.
se completó el primer mapa del epigenoma humano, es decir el registro de los cambios químicos en material genético, equivalentes a interruptores moleculares de los genes, lo que permitiría avanzar en la investigación del cáncer a partir de células madre para formar folículos pilosos, lo que apunta a generar el crecimiento de cabello en personas que padecen calvicie. -
 descubrimiento de 47 nuevos grandes grupos de bacterias en muestras tomadas en un acuífero cercano al pueblo de Rifle, en Colorado. Estos hayazgos permitirían entender mejor el papel que desempeñan los microbios subterráneos y perfeccionar los “modelos predictivos del clima a escala global y de los diferentes ciclos del carbono, el hidrógeno, el nitrógeno y el azufre.
descubrimiento de 47 nuevos grandes grupos de bacterias en muestras tomadas en un acuífero cercano al pueblo de Rifle, en Colorado. Estos hayazgos permitirían entender mejor el papel que desempeñan los microbios subterráneos y perfeccionar los “modelos predictivos del clima a escala global y de los diferentes ciclos del carbono, el hidrógeno, el nitrógeno y el azufre. -
 La edición genética
La edición genética
Y otro gran avance ha sido la aplicación en el campo de la medicina de la mejor técnica de la historia para "editar" genes. Es decir, se trata de una especie de "tijera molecular" que permite ya cortar el gen "defectuoso" (el que provoca una enfermedad como la diebetes) y poner en su lugar el gen "bueno" para intentar curar esta dolencia. -
 Superbacterias
Superbacterias
un importante paso para acabar con las "superbacterias", es decir, aquellas que son capaces de resistir el ataque de los antibióticos.Los científicos han diseñado moléculas capaces de fulminar la maquinaria celular que lleva a estas bacterias a no verse afectadas por los antibióticos convencionales. -
 Hayazgo mostró luz sobre su verdadera identidad: se trata del animal más antiguo de la Tierra, llamado Dickinsonia, que vivió hace 550 millones de años. La extraña criatura medía casi un metro y medio y era ovalada, con una gran cantidad de finas crestas a cada lado de una línea central. Probablemente yacía en el fondo de aguas marinas y se alimentaba de algas y cianobacterias, aunque se desconoce si tenía boca y tripa o simplemente absorbía la comida a través de su piel.
Hayazgo mostró luz sobre su verdadera identidad: se trata del animal más antiguo de la Tierra, llamado Dickinsonia, que vivió hace 550 millones de años. La extraña criatura medía casi un metro y medio y era ovalada, con una gran cantidad de finas crestas a cada lado de una línea central. Probablemente yacía en el fondo de aguas marinas y se alimentaba de algas y cianobacterias, aunque se desconoce si tenía boca y tripa o simplemente absorbía la comida a través de su piel. -
 Sumergirse dentro del sistema celular humano
Sumergirse dentro del sistema celular humano
La combinación de tres tecnologías, que se conoce como «single cell RNA-seq», es el avance científico más importante de todo 2018, según Science, ya que permiten conocer "la vida íntima" de las células y poder ver el desarrollo embrionario con máximo detalle. -
 la aprobación de un tratamiento eficaz para la mayoría de los casos de fibrosis quística (FQ), una enfermedad potencialmente mortal que provoca la acumulación de moco espeso y pegajoso en los pulmones, el tubo digestivo y otras áreas del cuerpo
la aprobación de un tratamiento eficaz para la mayoría de los casos de fibrosis quística (FQ), una enfermedad potencialmente mortal que provoca la acumulación de moco espeso y pegajoso en los pulmones, el tubo digestivo y otras áreas del cuerpo -
 un equipo de expertos en Japón logró cultivar un microbio marino y secuenció su genoma. Se trata del microorganismo conocido como 'Lokiarchaeota', perteneciente a una nueva categoría de las arqueas, un dominio que comparte características tanto de los organismos procariotas como de los eucariotas
un equipo de expertos en Japón logró cultivar un microbio marino y secuenció su genoma. Se trata del microorganismo conocido como 'Lokiarchaeota', perteneciente a una nueva categoría de las arqueas, un dominio que comparte características tanto de los organismos procariotas como de los eucariotas -
 Los expertos identificaron primero quince tipos de bacterias que caracterizan a un microbioma intestinal maduro así como marcadores sanguíneos que indican una recuperación en los efectos de la desnutrición.
Los expertos identificaron primero quince tipos de bacterias que caracterizan a un microbioma intestinal maduro así como marcadores sanguíneos que indican una recuperación en los efectos de la desnutrición.
Identificaron suplementos que contienen garbanzos, plátanos, soja y harina de cacahuete ayudaron a que los microbios maduraran. Después ensayo clínico, los niños que recibieron los suplementos tenían más proteínas en la sangre y metabolitos. -
 Inteligencia artificial para entender las proteínas, Una mejor comprensión de las formas de las proteínas podría desempeñar un papel fundamental en el desarrollo de nuevos fármacos para tratar enfermedades.
Inteligencia artificial para entender las proteínas, Una mejor comprensión de las formas de las proteínas podría desempeñar un papel fundamental en el desarrollo de nuevos fármacos para tratar enfermedades. -
 Las tijeras genéticas
Las tijeras genéticas
Las tijeras genéticas CRISPR / Casi han revolucionado las ciencias de la vida molecular, brindado nuevas oportunidades para el fitomejoramiento (mejoramiento genético de plantas), contribuyendo a terapias innovadoras contra el cáncer y pueden hacer realidad el sueño de curar enfermedades hereditarias. -
 Diferentes tipos de mascarillas “bloquean el virus en grados diferentes, pero todas bloquean la entrada del virus”, Si las partículas de virus traspasan estas barreras, dijo, la enfermedad podría ser más leve.
Diferentes tipos de mascarillas “bloquean el virus en grados diferentes, pero todas bloquean la entrada del virus”, Si las partículas de virus traspasan estas barreras, dijo, la enfermedad podría ser más leve. -
 funcionarios de salud en Wuhan, China, publicaron en línea la secuencia genética de lo que ahora se conoce como SARS-CoV-2. Así, en cuestión de horas, se inició la búsqueda de una vacuna contra el Covid-19.
funcionarios de salud en Wuhan, China, publicaron en línea la secuencia genética de lo que ahora se conoce como SARS-CoV-2. Así, en cuestión de horas, se inició la búsqueda de una vacuna contra el Covid-19. -
 se pondrá en órbita el James Webb, un telescopio espacial destinado a ser el sucesor del insigne Hubble. La idea de situarlo fuera de la atmósfera terrestre busca evitar las distorsiones producidas por la atmósfera. Esto y la tecnología puntera con la que ha sido diseñado, permitirán que veamos más lejos que nunca en la profundidad del cosmos, permitiéndonos tomar imágenes directas de planetas externos a nuestro sistema solar y estudiar cómo se forman las estrellas.
se pondrá en órbita el James Webb, un telescopio espacial destinado a ser el sucesor del insigne Hubble. La idea de situarlo fuera de la atmósfera terrestre busca evitar las distorsiones producidas por la atmósfera. Esto y la tecnología puntera con la que ha sido diseñado, permitirán que veamos más lejos que nunca en la profundidad del cosmos, permitiéndonos tomar imágenes directas de planetas externos a nuestro sistema solar y estudiar cómo se forman las estrellas. -
 En tiempo récord, el poder del ingenio humano ha sido capaz de salir al paso del azote del coronavirus SARS-CoV-2 con infinidad de vacunas, algunas de las cuales ya se están distribuyendo por el mundo o lo harán en breve: Pfizer-BioNTech, Moderna-NIAID, Sinopharm, Sinovac o la Sputnik V de Rusia. A lo largo del año seguirán las de Oxford-AstraZeneca, Novavax, Janssen y otras.
En tiempo récord, el poder del ingenio humano ha sido capaz de salir al paso del azote del coronavirus SARS-CoV-2 con infinidad de vacunas, algunas de las cuales ya se están distribuyendo por el mundo o lo harán en breve: Pfizer-BioNTech, Moderna-NIAID, Sinopharm, Sinovac o la Sputnik V de Rusia. A lo largo del año seguirán las de Oxford-AstraZeneca, Novavax, Janssen y otras.
Want to make a timeline like this?
Use Timetoast to turn dates, events, milestones, and phases into a clear visual timeline you can build and share. Timetoast is a timeline maker for work, school, research, and stories.
